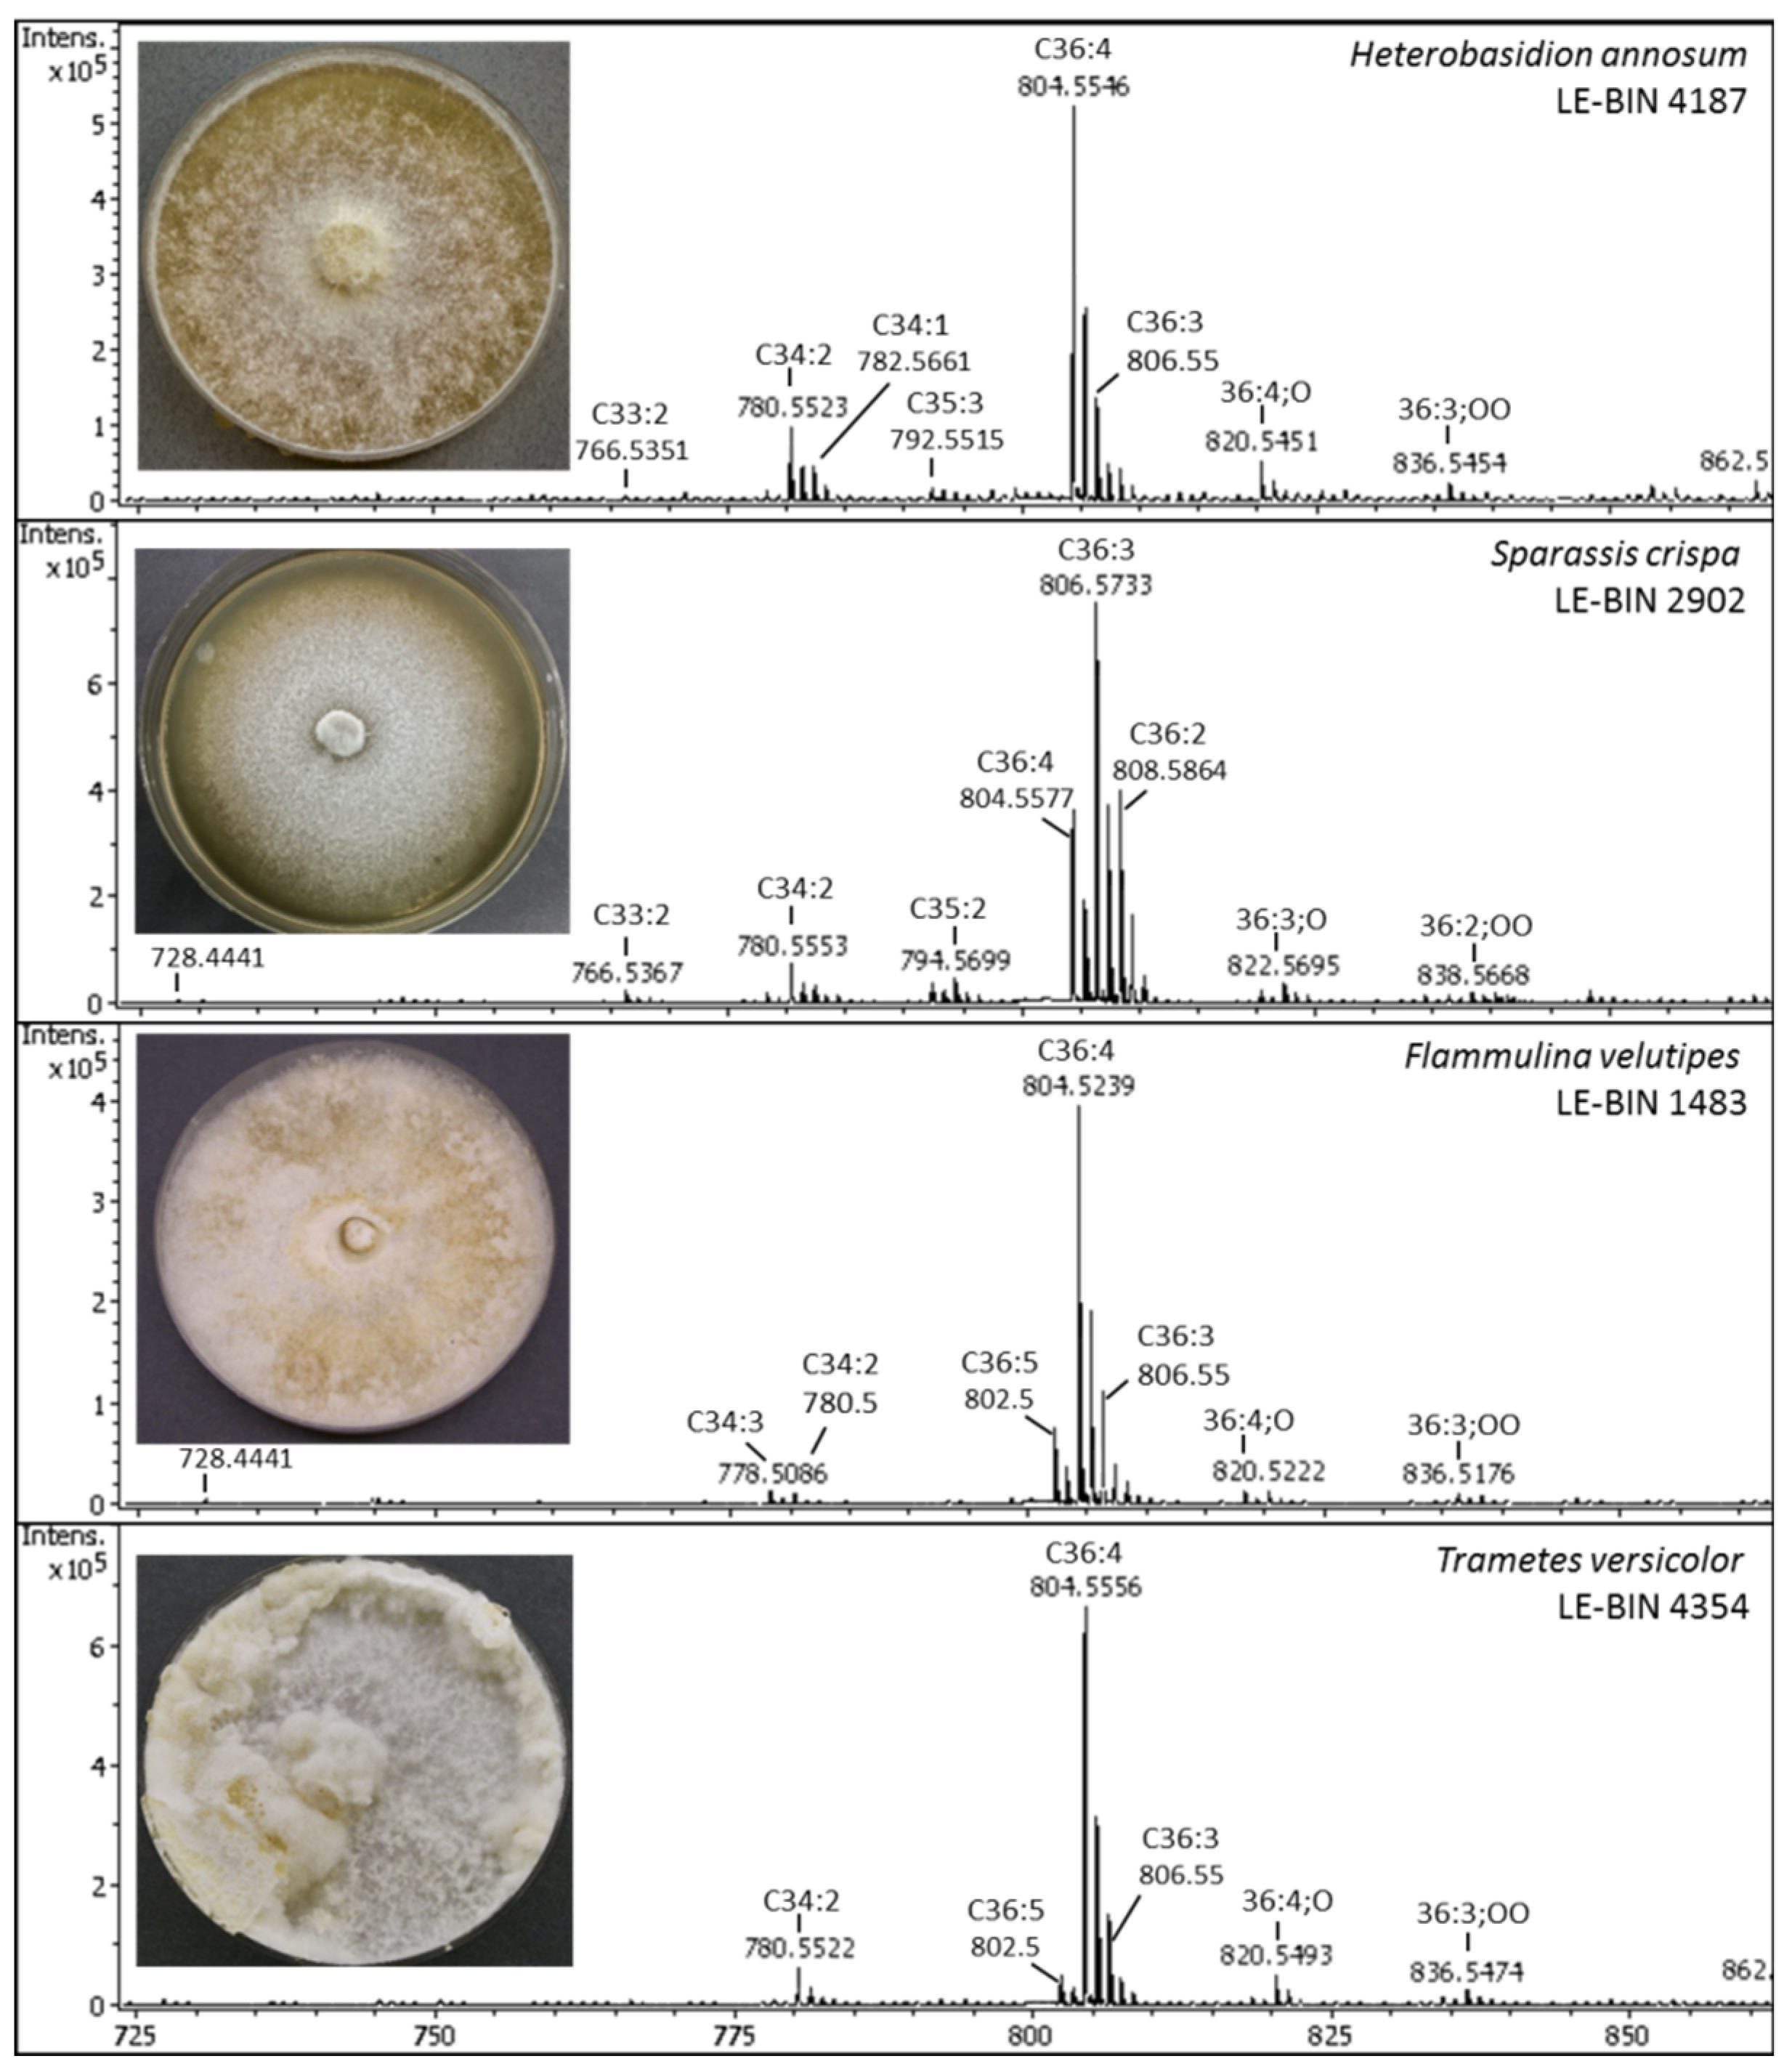
Jof 08 00177 g002 550

Diversity of ESI-MS Based Phosphatidylcholine Profiles in Basidiomycetes
Abstract
:1. Introduction
2. Materials and Methods
2.1. Fungal Strains and Culture Conditions
2.2. Lipid Extraction and Fractionating
2.3. ESI-MS Analyses of PC Molecular Species
2.4. Statistics
3. Results and Discussion
3.1. PC Molecular Species Diversity
3.2. Comparative Analyses, Typing and Clustering of PC Profiles
Supplementary Materials
Author Contributions
Funding
Institutional Review Board Statement
Informed Consent Statement
Acknowledgments
Conflicts of Interest
References
- Renne, M.F.; de Kroon, A.I.P.M. The role of phospholipid molecular species in determining the physical properties of yeast membranes. FEBS Lett. 2018, 592, 1330–1345. [Google Scholar] [CrossRef] [PubMed] [Green Version]
- McMaster, C.R. From yeast to humans—Roles of the Kennedy pathway for phosphatidylcholine synthesis. FEBS Lett. 2017, 592, 1256–1272. [Google Scholar] [CrossRef] [PubMed] [Green Version]
- Thompson, M.J.; Baenziger, J.E. Structural basis for the modulation of pentameric ligand-gated ion channel function by lipids. Biochim. Biophys. Acta (BBA) Biomembr. 2020, 1862, 183304. [Google Scholar] [CrossRef] [PubMed]
- Harayama, T.; Riezman, H. Understanding the diversity of membrane lipid composition. Mol. Cell Biol. 2018, 19, 281–296. [Google Scholar] [CrossRef]
- Raghunathana, K.; Kenworthy, A. Dynamic pattern generation in cell membranes: Current insights into membrane organization. BBA Biomembr. 2018, 1860, 2018–2031. [Google Scholar] [CrossRef]
- Cassim, A.; Gouguet, P.; Gronnier, J.; Laurent, N.; Germain, V.; Grisona, M.; Bouttea, Y.; Gerbeau-Pissot, P.; Simon-Plas, F.; Mongrand, S. Plant lipids: Key players of plasma membrane organization and function. Prog Lipid Res. 2019, 73, 1–27. [Google Scholar] [CrossRef]
- Senik, S.V.; Maloshenok, L.G.; Kotlova, E.R.; Shavarda, A.L.; Moiseenko, K.V.; Bruskin, S.A.; Koroleva, O.V.; Psurtseva, N.V. Diacylglyceryltrimethylhomoserine content and gene expression changes triggered by phosphate deprivation in the mycelium of the basidiomycete Flammulina velutipes. Phytochemistry 2015, 117, 34–42. [Google Scholar] [CrossRef]
- Senik, S.V.; Psurtseva, N.V.; Shavarda, A.L.; Kotlova, E.R. Role of lipids in the thermal plasticity of basidial fungus Favolaschia manipularis. Can. J. Microbiol. 2019, 65, 870–879. [Google Scholar] [CrossRef]
- Wołczańska, A.; Christie, W.W.; Fuchs, B.; Galuska, C.E.; Kowalczyk, B.; Palusińska-Szysz, M. Fatty acid composition and lipid profiles as chemotaxonomic markers of phytopathogenic fungi Puccinia malvacearum and P. glechomatis. Fungal Biol. 2021, 125, 869–878. [Google Scholar] [CrossRef]
- Kotlova, E.R.; Senik, S.V.; Kücher, T.; Shavarda, A.L.; Kiyashko, A.A.; Psurtseva, N.V.; Sinyutina, N.F.; Zubarev, R.A. Alterations in the composition of membrane glycero- and sphingolipids in the course of Flammulina velutipes surface culture development. Microbiology 2009, 78, 193–201. [Google Scholar] [CrossRef]
- Binks, P.R.; Robson, G.D.; Goosey, M.W.; Trinci, A.P. Relationships between phosphatidylcholine content, chitin synthesis, growth, and morphology of Aspergillus nidulans choC. FEMS Microbiol. Lett. 1991, 67, 159–164. [Google Scholar] [CrossRef] [PubMed] [Green Version]
- Ridgway, N.D. The role of phosphatidylcholine and choline metabolites to cell proliferation and survival. Crit. Rev. Biochem. Mol. Biol. 2012, 48, 20–38. [Google Scholar] [CrossRef] [PubMed]
- Senik, S.V.; Kolker, T.L.; Kotlova, E.R.; Vlasov, D.Y.; Shavarda, A.L.; Puzansky, R.K.; Psurtseva, N.V. Lipid and metabolite profiling of Serpula lacrymans under freezing stress. Curr. Microbiol. 2021, 789, 61–966. [Google Scholar] [CrossRef]
- de Mendoza, D.; Pilon, M. Control of membrane lipid homeostasis by lipid-bilayer associated sensors: A mechanism conserved from bacteria to humans. Prog. Lipid Res. 2019, 76, 100996. [Google Scholar] [CrossRef]
- Furse, S.; De Kroon, A.I.P.M. Phosphatidylcholine’s functions beyond that of a membrane brick. Mol. Membr. Biol. 2015, 32, 117–119. [Google Scholar] [CrossRef]
- Lagace, T.A.; Ridgway, N. The role of phospholipids in the biological activity and structure of the endoplasmic reticulum. Biochim. Biophys. Acta 2013, 1833, 2499–2510. [Google Scholar] [CrossRef] [Green Version]
- Wolf, J.M.; Espadas, J.; Luque-Garcia, J.; Reynolds, T.; Casadevall, A. Lipid Biosynthetic Genes Affect Candida albicans Extracellular Vesicle Morphology, Cargo, and Immunostimulatory Properties. Eukaryot. Cell 2015, 14, 745–754. [Google Scholar] [CrossRef] [Green Version]
- Minder, A.C.; de Rudder, K.E.E.; Narberhaus, F.; Fischer, H.M.; Hennecke, H.; Geiger, O. Phosphatidylcholine level in Bradyrhizobium japonicum membranes are critical for an efficient symbiosis with the soybean host plant. Mol. Microbiol. 2001, 39, 1186–1198. [Google Scholar] [CrossRef] [PubMed]
- DeLong, C.J.; Shen, Y.J.; Thomas, M.J.; Cui, Z. Molecular distinction of phosphatidylcholine synthesis between the CDP-Choline pathway and phosphatidylethanolamine methylation pathway. J. Biol. Chem. 1999, 274, 29683–29688. [Google Scholar] [CrossRef] [Green Version]
- Bleijerveld, O.B.; Brouwers, J.F.; Vaandrager, A.B.; Helms, J.B.; Houweling, M. The CDP-ethanolamine pathway and phosphatidylserine decarboxylation generate different phosphatidylethanolamine molecular species. J. Biol. Chem. 2007, 282, 28362–28372. [Google Scholar] [CrossRef] [Green Version]
- Řezanka, T.; Kolouchova, I.; Gharwalova, L.; Palyzová, A.; Sigler, K. Lipidomic Analysis: From Archaea to Mammals. Lipids 2018, 53, 5–25. [Google Scholar] [CrossRef] [PubMed]
- Lin, H.-C.; Hewage, R.T.; Lu, Y.-C.; Chooi, Y.-H. Biosynthesis of bioactive natural products from Basidiomycota. Org. Biomol. Chem. 2019, 17, 1027–1036. [Google Scholar] [CrossRef] [PubMed]
- Nichols, B.W. Separation of the lipids of photosynthetic tissues: Improvements in analysis by thin-layer chromatography. Biochim. Biophys. Acta 1963, 70, 417–425. [Google Scholar] [CrossRef]
- Accumulation of a novel glycolipid and a betaine lipid in cell of Rhodobacter sphaeroides grown under phosphate limitation. Arch. Biochem. Biophys. 1995, 317, 103–111. [CrossRef]
- Liebisch, G.; Fahy, E.; Aoki, J.; Dennis, E.A.; Durand, T.; Ejsing, C.S.; Fedorova, M.; Feussner, I.; Griffiths, W.J.; Köfeler, H.; et al. Update on LIPID MAPS classification, nomenclature, and shorthand notation for MS-derived lipid structures. J. Lipid Res. 2020, 61, 1539–1555. [Google Scholar] [CrossRef]
- R Core Team. R: A Language and Environment for Statistical Computing; R Foundation for Statistical Computing: Vienna, Austria, 2021; Available online: https://www.R-project.org/ (accessed on 20 December 2021).
- Stacklies, W.; Redestig, H.; Scholz, M.; Walther, D.; Selbig, J. PcaMethods—A Bioconductor package providing PCA methods for incomplete data. Bioinformatics 2007, 23, 1164–1167. [Google Scholar] [CrossRef]
- Oksanen, J.F.; Blanchet, G.; Friendly, M.; Kindt, R.; Legendre, P.; McGlinn, D.; Minchin, P.R.; O’Hara, R.B.; Simpson, G.L.; Solymos, P.; et al. Vegan: Community Ecology Package. R Package Version 2.5-7. 2020. Available online: https://CRAN.R-project.org/package=vegan (accessed on 20 December 2021).
- Gu, Z.; Eils, R.; Schlesner, M. Complex heatmaps reveal patterns and correlations in multidimensional genomic data. Bioinformatics 2016, 32, 2847–2849. [Google Scholar] [CrossRef] [Green Version]
- He, M.-Q.; Zhao, R.-L.; Hyde, K.D.; Begerow, D.; Kemler, M.; Yurkov, A.; McKenzie, E.H.C.; Raspé, O.; Kakishima, M.; Sánchez-Ramírez, S.; et al. Notes, outline and divergence times of Basidiomycota. Fungal Divers. 2019, 99, 105–367. [Google Scholar] [CrossRef] [Green Version]
- Klose, C.; Surma, M.A.; Gerl, M.J.; Meyenhofer, F.; Shevchenko, A.; Simons, K. Flexibility of a Eukaryotic Lipidome—Insights from Yeast Lipidomics. PLoS ONE 2012, 7, e35063. [Google Scholar] [CrossRef] [Green Version]
- De Smet, C.H.; Cox, R.; Brouwers, J.F.; de Kroon, A.I. Yeast cells accumulate excess endogenous palmitate in phosphatidylcholine by acyl chain remodeling involving the phospholipase B Plb1p. Biochim. Biophys. Acta (BBA)—Mol. Cell Biol. Lipids 2013, 1831, 1167–1176. [Google Scholar] [CrossRef]
- Anaokar, S.; Kodali, R.; Jonik, B.; Renne, M.F.; Brouwers, J.F.; Lager, I.; de Kroon, A.I.; Patton-Vogt, J. The glycerophosphocholine acyltransferase Gpc1 is part of a phosphatidylcholine (PC)-remodeling pathway that alters PC species in yeast. J. Biol. Chem. 2019, 294, 1189–1201. [Google Scholar] [CrossRef] [Green Version]
- Gao, Q.; Lu, Y.; Yao, H.; Xu, Y.-J.; Huang, W.; Wang, C. Phospholipid homeostasis maintains cell polarity, development and virulence in Metarhizum robertsii. Environ. Microbiol. 2016, 18, 3976–3990. [Google Scholar] [CrossRef] [PubMed]
- Frolova, G.M.; Kotlova, E.R.; Sokornova, S.V.; Senik, S.V.; Shavarda, A.L.; Misharev, A.D.; Berestetskiy, A.O. Pathogenicity and Lipid Composition of Mycelium of the Fungus Stagonospora cirsii VIZR 1.41 during Submerged Cultivation. Appl. Biochem. Microbiol. 2021, 57, 226–235. [Google Scholar] [CrossRef]
- Gryz, E.; Perlińska-Lenart, U.; Gawarecka, K.; Jozwiak, A.; Piłsyk, S.; Lipko, A.; Jemiola-Rzeminska, M.; Bernat, P.; Muszewska, A.; Steczkiewicz, K.; et al. Poly-Saturated Dolichols from Filamentous Fungi Modulate Activity of Dolichol-Dependent Glycosyltransferase and Physical Properties of Membranes. Int. J. Mol. Sci. 2019, 20, 3043. [Google Scholar] [CrossRef] [Green Version]
- Celis Ramírez, A.M.; Amézquita, A.; Cardona Jaramillo, J.E.C.; Matiz-Cerón, L.F.; Andrade-Martínez, J.S.; Triana, S.; Mantilla, M.J.; Restrepo, S.; Barrios, A.F.G.; de Cock, H. Analysis of Malassezia Lipidome Disclosed Differences Among the Species and Reveals Presence of Unusual Yeast Lipids. Front. Cell. Infect. Microbiol. 2020, 10, 338. [Google Scholar] [CrossRef]
- Yamashita, A.; Hayashi, Y.; Nemoto-Sasaki, Y.; Ito, M.; Oka, S.; Tanikawa, T.; Waku, K.; Sugiura, T. Acyltransferases and transacylases that determine the fatty acid composition of glycerolipids and the metabolism of bioactive lipid mediators in mammalian cells and model organisms. Prog. Lipid Res. 2014, 53, 18–81. [Google Scholar] [CrossRef] [PubMed]
- Głąb, B.; Beganovic, M.; Anaokar, S.; Hao, M.-S.; Rasmusson, A.G.; Patton-Vogt, J.; Banaś, A.; Stymne, S.; Lager, I. Cloning of Glycerophosphocholine Acyltransferase (GPCAT) from Fungi and Plants. J. Biol. Chem. 2016, 291, 25066–25076. [Google Scholar] [CrossRef] [Green Version]
- Senik, S.V.; Kotlova, E.R.; Novikov, A.V.; Shavarda, A.L.; Psurtseva, N.V. Formation of Diacylglyceryltrimethylhomoserines in the Surface Culture of the Basidiomycete Flammulina velutipes. Mikrobiologiya 2012, 81, 578–586. [Google Scholar] [CrossRef]
- Dembitsky, V.M.; Shubina, E.E.; Kashin, A.G. Phospholipid and fatty acid compositions of some Basidiomycetes. Phytochemistry 1992, 31, 845–849. [Google Scholar] [CrossRef]
- Sakai, H.; Kajiwara, S. Membrane lipid profile of an edible Basidiomycete Lentinula edodes during growth and cell differentiation. Lipids 2004, 39, 67–73. [Google Scholar] [CrossRef]
- Sande, D.; de Oliveira, G.P.; e Moura, M.A.F.; Martins, B.D.A.; Lima, M.T.N.S.; Takahashi, J.A. Edible mushrooms as a ubiquitous source of essential fatty acids. Food Res. Int. 2019, 125, 108524. [Google Scholar] [CrossRef] [PubMed]
- Dimitrijevic, M.V.; Mitic, V.D.; Jovanovic, O.P.; Stankov Jovanovic, V.P.; Nikolic, J.S.; Petrovic, G.M.; Stojanovic, G.S. Comparative study of fatty acids profile in eleven wild mushrooms of Boletaceae and Russulaceae famalies. Chem. Biodivers. 2018, 15, e1700434. [Google Scholar] [CrossRef] [PubMed]
- Marekov, I.; Momchilova, S.; Grund, B.; Nikolova-Damyanova, B. Fatty acid composition of wild mushroom species of order Agaricales—Examination by gas chromatography-mass spectrometry and chemometrics. J. Chromatogr. B. 2012, 910, 54–60. [Google Scholar] [CrossRef] [PubMed]



| Order | Family | Species | Trophic Group c | Ecology d | Type of Rot e | Growth f | Hyphal System g | m/z [M+Na]+/Structure a | ||||||
|---|---|---|---|---|---|---|---|---|---|---|---|---|---|---|
| 778.5/ 34:3 | 780.6/ 34:2 | 782.6/ 34:1 | 802.5/ 36:5 | 804.6/ 36:4 | 806.6/ 36:3 | 808.6/ 36:2 | ||||||||
| Agaricales | Entolomataceae | Entoloma abortivum 4158 | Mm | P | WR | S | MM | 0.49 | 4.33 | 1.08 | 1.72 | 77.83 | 1.23 | 0.09 |
| Lycoperdaceae | Lycoperdon perlatum 2884 | Hu | S | WR | S | MM | 0.65 | 8.79 | 0.86 | 0.84 | 64.68 | 2.18 | 1.76 | |
| Schizophyllaceae | Schizophyllum commune 2961 | Le | S | WR | F | MM | nd b | 15.89 | 5.00 | 6.11 | 45.19 | 13.48 | 3.54 | |
| Mycenaceae | Mycena galopus 2249 | St | S | WR | S | MM | 2.09 | 4.74 | 0.42 | 1.83 | 71.86 | 4.00 | 1.54 | |
| Tricholomataceae | Leucopaxillus laterarius 3838 | Hu | S | WR | M | MM | nd | 9.14 | 2.07 | nd | 57.04 | 4.18 | 11.08 | |
| Bolbitiaceae | Conocybe watlingii 2444 | Hu | S | WR | S | MM | 0.91 | 3.64 | 0.79 | 1.85 | 74.34 | 3.20 | 0.95 | |
| Omphalotaceae | Gymnopus dryophilus 2176 | St | S | WR | S | MM | 1.94 | 2.82 | 0.74 | 1.50 | 55.64 | 22.33 | 2.10 | |
| Omphalotaceae | Panellus luxfilamentus 4307 | Le | S | WR | S | MM | nd | 9.06 | 4.20 | nd | 42.01 | 15.27 | 4.20 | |
| Omphalotaceae | Collybiopsis menehune 4436 | St | S | WR | S | MM | 6.45 | 5.71 | 0.74 | 2.42 | 65.84 | 2.06 | 1.88 | |
| Pterulaceae | Radulomyces copelandii 3899 | Le | S | WR | MM | 1.81 | 3.05 | 2.46 | nd | 55.58 | 23.66 | 2.53 | ||
| Pterulaceae | Pterulicium echo 4235 | Le | S | WR | F | DM | 2.00 | 5.85 | 1.57 | nd | 58.30 | 15.00 | 2.08 | |
| Physalacriacerae | Flammulina velutipes 1483 | Le | S | WR | F | MM | 1.88 | 5.77 | 1.39 | 10.80 | 52.79 | 10.47 | 2.62 | |
| Auriculariales | Auriculariaceae | Auricularia mesenterica 2115 | Le | S | WR | M | MM | 0.92 | 5.42 | 2.44 | 0.93 | 44.79 | 30.31 | 2.97 |
| Cantharellales | Hydnaceae | Rogersiomyces malaysianus 3507 | St | S | BR | S | MM | 0.14 | nd | 0.78 | 1.77 | 74.45 | 5.17 | 2.32 |
| Gloeophyllales | Gloeophyllaceae | Gloeophyllum trabeum 0157 | Le | S | BR | M | DM | 1.86 | 13.34 | 5.02 | nd | 33.94 | 24.19 | 3.66 |
| Gloeophyllaceae | Gloeophyllum sepiarium 3667 | Le | S | BR | M | TM | 1.63 | 8.23 | 2.99 | 1.48 | 47.09 | 19.57 | 4.25 | |
| Phallales | Phallaceae | Phallus impudicus 4116 | Hu | S | WR | S | MM | 1.27 | 3.15 | 1.06 | nd | 55.07 | 16.73 | 0.72 |
| Polyporales | Laetiporaceae | Laetiporus sulphureus 3867 | Le | P | BR | M | DM | 0.23 | 2.69 | 0.65 | 0.98 | 35.90 | 33.74 | 8.66 |
| Irpecaceae | Irpex lacteus 4341 | Le | S | WR | F | DM | 2.69 | 7.06 | 4.95 | 0.76 | 26.26 | 35.59 | 8.98 | |
| Dacryobolaceae | Tyromyces lacteus 3990 | Le | S | BR | S | MM | 3.48 | 6.19 | 2.14 | nd | 15.44 | 39.23 | 22.97 | |
| Polyporaceae | Grammothele lineata 4219 | Le | S | WR | F | DM | 1.10 | 1.66 | 0.83 | 2.44 | 50.60 | 21.89 | 3.47 | |
| Polyporaceae | Trametes versicolor 2782 | Le | S | WR | F | TM | 1.37 | 6.43 | 2.01 | 1.41 | 54.88 | 15.33 | 1.21 | |
| Polyporaceae | Trametes versicolor 4354 | Le | S | WR | F | TM | 1.27 | 6.34 | 1.21 | nd | 67.04 | 6.39 | 1.34 | |
| Polyporaceae | Trametes hirsuta 4124 | Le | S | WR | M | TM | 2.03 | 8.94 | 1.96 | 6.94 | 52.12 | 10.64 | 1.39 | |
| Polyporaceae | Trametes trogii 3607 | Le | S | WR | F | TM | 3.75 | 3.89 | 3.93 | nd | 46.52 | 24.55 | 5.81 | |
| Polyporaceae | Funalia aspera 4247 | Le | S | WR | M | TM | 1.34 | 6.17 | 2.43 | 2.94 | 48.45 | 18.65 | 2.60 | |
| Phanerochaetaceae | Terana coerulea 2820 | Le | S | WR | M | MM | 0.64 | 8.09 | 2.44 | nd | 49.72 | 13.89 | 4.27 | |
| Phanerochaetaceae | Bjerkandera adusta 3996 | Le | S | WR | F | MM | 0.75 | 3.75 | 0.88 | 1.26 | 69.20 | 0.18 | 0.29 | |
| Steccherinaceae | Steccherinum ochraceum 3174 | Le | S | WR | S | DM | 2.31 | 21.52 | 1.70 | 1.62 | 40.05 | 13.84 | 2.52 | |
| Fomitopsidaceae | Fomitopsis pinicola 4361 | Le | S | BR | F | DM | nd | 2.39 | 0.67 | 4.05 | 59.82 | 20.20 | 2.43 | |
| Sparassidaceae | Sparassis crispa 2902 | Le | P | BR | S | MM | 0.96 | 4.32 | 1.20 | 0.58 | 19.21 | 40.69 | 16.69 | |
| Meruliaceae | Mycoacia aurea 4224 | Le | S | WR | M | MM | 0.84 | 12.74 | 0.86 | 2.00 | 56.14 | 1.45 | 1.19 | |
| Meripilaceae | Meripilus giganteus 2665 | Le | P | WR | F | MM | nd | 2.84 | 1.34 | 0.96 | 77.65 | 8.43 | 0.20 | |
| Incrustoporiaceae | Skeletocutis odora 4421 | Le | S | WR | S | DM | nd | 12.86 | 6.18 | nd | 64.69 | 2.47 | 0.93 | |
| Russulales | Auriscalpiaceae | Auriscalpium vulgare 3627 | St | S | WR | S | DM | 1.31 | 2.35 | 0.81 | 15.42 | 60.71 | 9.84 | 0.48 |
| Hericiaceae | Hericium coralloides 3594 | Le | S | WR | S | MM | 1.49 | 6.68 | 1.55 | nd | 46.05 | 20.44 | 4.70 | |
| Hericiaceae | Dentipellis fragilis 3869 | Le | S | WR | M | MM | 2.53 | 5.61 | 1.37 | 3.11 | 30.34 | 30.30 | 9.31 | |
| Bondarzewiaceae | Heterobasidion annosum 4187 | Le | P | WR | M | DM | 1.62 | 10.33 | 4.01 | 1.29 | 54.60 | 6.91 | 3.68 | |
| Bondarzewiaceae | Laurilia sulcata 3530 | Le | S | WR | M | TM | 0.71 | 7.06 | 2.06 | 1.08 | 63.89 | 9.27 | 2.32 | |
Publisher’s Note: MDPI stays neutral with regard to jurisdictional claims in published maps and institutional affiliations. |
© 2022 by the authors. Licensee MDPI, Basel, Switzerland. This article is an open access article distributed under the terms and conditions of the Creative Commons Attribution (CC BY) license (https://creativecommons.org/licenses/by/4.0/).
Share and Cite
Kotlova, E.R.; Senik, S.V.; Manzhieva, B.S.; Kiyashko, A.A.; Shakhova, N.V.; Puzansky, R.K.; Volobuev, S.V.; Misharev, A.D.; Serebryakov, E.B.; Psurtseva, N.V. Diversity of ESI-MS Based Phosphatidylcholine Profiles in Basidiomycetes. J. Fungi 2022, 8, 177. https://doi.org/10.3390/jof8020177
Kotlova ER, Senik SV, Manzhieva BS, Kiyashko AA, Shakhova NV, Puzansky RK, Volobuev SV, Misharev AD, Serebryakov EB, Psurtseva NV. Diversity of ESI-MS Based Phosphatidylcholine Profiles in Basidiomycetes. Journal of Fungi. 2022; 8(2):177. https://doi.org/10.3390/jof8020177
Chicago/Turabian StyleKotlova, Ekaterina R., Svetlana V. Senik, Bairta S. Manzhieva, Anna A. Kiyashko, Natalia V. Shakhova, Roman K. Puzansky, Sergei V. Volobuev, Alexander D. Misharev, Eugeny B. Serebryakov, and Nadezhda V. Psurtseva. 2022. "Diversity of ESI-MS Based Phosphatidylcholine Profiles in Basidiomycetes" Journal of Fungi 8, no. 2: 177. https://doi.org/10.3390/jof8020177
APA StyleKotlova, E. R., Senik, S. V., Manzhieva, B. S., Kiyashko, A. A., Shakhova, N. V., Puzansky, R. K., Volobuev, S. V., Misharev, A. D., Serebryakov, E. B., & Psurtseva, N. V. (2022). Diversity of ESI-MS Based Phosphatidylcholine Profiles in Basidiomycetes. Journal of Fungi, 8(2), 177. https://doi.org/10.3390/jof8020177






